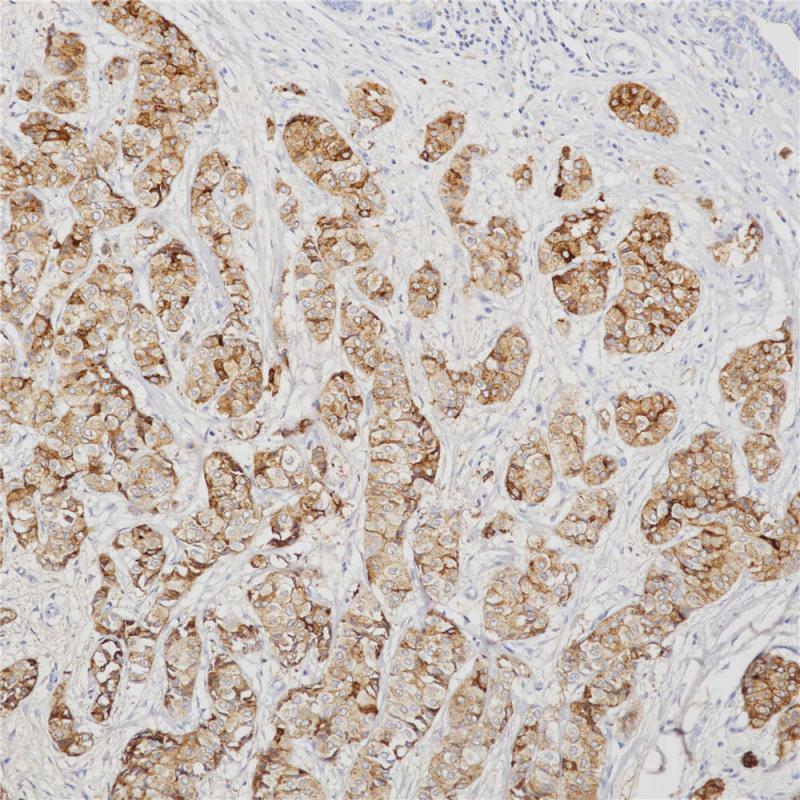
乳腺癌 GCDFP-15 (BP6118) 染色

产品中心
乳腺癌 GCDFP-15 (BP6118) 染色
GCDFP-15 重组兔单克隆抗体
GCDFP-15即gross cystic disease fluid protein 15,是泌乳素诱导蛋白家族中的一员。GCDFP-15抗原可表达于非肿瘤性浆液性涎腺腺体、精囊和乳腺以及乳腺囊肿液等中,可作为乳腺癌标记物。该抗体主要用于乳腺癌的诊断,也常与mammaglobin 联用以判断乳腺癌微小病灶的转移情况。
Specifications
- 目录号
- BX50114
- 克隆号
- BP6118
- 阳性对照
- 乳腺癌
- 亚细胞定位
- 细胞质
- 组织类型
- FFPE
- 修复方式
- HIER
- 稀释比
- 1:100-1:200
- 规格
- 100μl/vial, 1ml/vial
- 用途
- RUO
Reference
1.Sapino A, Cassoni P and Bussolati G. Regul. Homeost. Agents. 2000; 14(4):259–262.
2.Haagensen DE Jr, Dilley WG, Mazoujian G et al. Ann. NY Acad. Sci. 1990;586:161–173.


